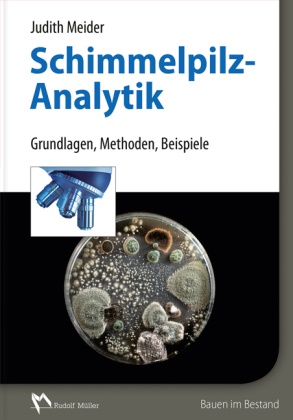

Ulteriori informazioni
Das vorliegende Werk schließt eine Lücke der vorliegenden Fachliteratur zum Thema Schimmelpilzschäden, die sich vorwiegend mit der Entstehung und Sanierung von derartigen Schäden befasst. Hier werden die erforderlichen Grundlagen der Schimmelpilzanalytik so beschrieben, dass Sachverständige bei einem Schadensfall künftig die richtigen Vorbereitungen treffen, die richtige Probenahme- und Analysemethoden wählen und die richtigen Schlussfolgerungen für ein nachhaltiges Sanierungskonzept ziehen. Das Buch bringt Vor- und Nachteile der jeweiligen Analysemethode auf den Punkt und ist damit eine äußerst praktische Navigationshilfe für alle, die am Bau Entscheidungen bei Schimmelpilzschäden treffen müssen. Es liefert ihnen das nötige Grundlagenwissen zur sachgerechten Vorgehensweise bei Verdacht auf Schimmelpilzschäden und im Schadensfall. Zudem gibt es praktische Tipps zu Probeentnahme und Bewertung der jeweiligen Analyseergebnisse. Die dabei am häugisten auftretenden Fragen werden zusammengefasst und eindeutig beantwortet. Die konkreten Praxisbeispiele bieten noch tieferen Einblick in die praktische Schimmelpilzanalytik.Aus dem Inhalt:- Grundlagen der Mikrobiologie von Feuchteschäden- Mikrobiologische Analytik von Feuchtigkeitsschäden- Probenentnahme für mikrobilogische Untersuchungen bei Feuchteschäden-PraxsibeispieleGlossar
Info autore
Judith Meider ist Geschäftsführerin der Labor Urbanus GmbH, Düsseldorf, deren Schwerpunkt in der Schimmelpilz- und Bakterienanalytik in Luft- und Materialproben aus Gebäuden besteht.